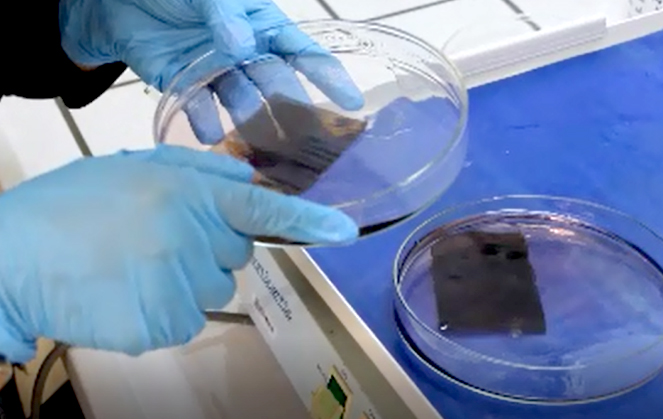

Laboratório de Bioquímica

QUEM SOMOS
Um laboratório de competências transversais vocacionado para a prestação de serviços, para a investigação e desenvolvimento de projetos, e para a transferência de conhecimento nas áreas científicas da Bioquímica e Genética.
O Laboratório de Bioquímica (LB) participa no desenvolvimento, validação e aplicação de metodologias bioquímicas e moleculares para a identificação de organismos nocivos e de qualidade, em culturas agrícolas e florestais, no âmbito dos Planos Oficiais de Controlo dos Laboratórios Nacionais de Referência da Sanidade Vegetal.
Na componente de investigação promove atividades de investigação fundamental e aplicada, com o objetivo de contribuir para programas de melhoramento genético, programas de conservação de recursos genéticos florestais e para seleção de genótipos de interesse económico e ecológico.
Colabora em atividades de ensino e formação, contribui para o intercâmbio de conhecimentos técnicos e científicos e participa com o seu conhecimento em serviços à comunidade.
MISSÃO
- Apoiar a execução dos Planos Nacionais de Controlo de organismos fitopatogénicos e/ou de quarentena, para certificação de material vegetal;
- Investir em projetos de investigação, procurando o avanço e a produção do conhecimento científico;
- Oferecer às entidades públicas e privadas dos setores florestal e agrícolas as mais atualizadas metodologias de diagnóstico, refletindo o compromisso com a melhoria da qualidade;
- Promover a formação a vários níveis, através da orientação de estagiários de licenciatura e pós-licenciatura (mestrandos e doutorandos) e de técnicos de entidades públicas ou privadas do sector agrícola e florestal.

VISÃO
- Apoio à concretização da missão de estado do INIAV, I.P. enquanto Laboratório Nacional de Referência.
OBJETIVOS
- Desenvolvimento, validação e implementação de novos marcadores bioquímicos e moleculares direcionados para o diagnóstico de organismos fitopatogénicos;
- Caracterização da diversidade genética de populações naturais e cultivares, seleção das plantas com características produtivas de interesse e suas relações com o ambiente;
- Análises genómicas e transcriptómicas, estudo das relações gene, organismo e ambiente;
- Divulgação do conhecimento científico no domínio da Sanidade Vegetal.
ÁREAS DE INTERVENÇÃO

INVESTIGAÇÃO
Conceção e participação em projetos de I&D.
PRESTAÇÃO DE SERVIÇOS
Análises laboratoriais em diversas matrizes (madeira, partes de plantas, insetos, nematodes, ácaros, fungos, etc.).
FORMAÇÃO
Ações de formação destinadas a diversos públicos-alvo e orientação e acompanhamento de mestrandos e doutorandos de diferentes nacionalidades.
Divulgação
Disseminação do conhecimento técnico-científico através de publicações em diversos formatos.
Ações de formação

Cursos

Divulgação à comunidade

Equipa e Contactos
Equipa
- Ana Rita Varela
- Maria José Silva

Contactos
Unidade Estratégica Investigação e Serviços de Sistemas Agrários e Florestais e Sanidade Vegetal (UEIS-SAFSV)
Av. da República, Quinta do Marquês - Edifício Florestal
2780-157 Oeiras – Portugal